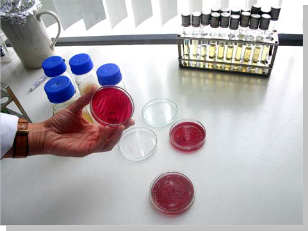

Питьевая вода и ее влияние на здоровье человека
- неорганічних речовин у питній воді;
- органічних речовин у питній воді;
- – будинковими лічильниками холодної води – 84 %;
- – будинковими лічильниками гарячої води – 15,6 %;
- – квартирними лічильниками холодної води – 40,5 %;
- – квартирними лічильниками гарячої води – 39 %.
- води і 3,5 кубічних метра гарячої води, на одну особу в місяць. Реальне споживання води, яке визначається за показами лічильників, у більшості випадків значно менше. Окрім того, при встановленні лічильників води спрацьовує психологічний фактор, коли споживач починає раціонально використовувати воду, що сприяє економії води.
- Порядок оплати робіт з повірки і монтажу-демонтажу лічильників регламентується у таких нормативних документах:
Вода є необхідною умовою і складовою частиною життя на Землі.
Здоров'я та благополуччя людей значною мірою залежить від водних ресурсів.
У результаті глобального техногенного впливу на природу вода, як її вагома життєдайна складова, зазнала і зазнає значних змін, що негативно впливають на діяльність та здоров'я людей. За даними Всесвітньої Організації Охорони Здоров'я (ВООЗ), щороку у світі біля 25% населення піддається ризику споживання неякісної питної води, а більше як 80% усіх захворювань людини безпосередньо пов'язано із вживанням неякісної води, до складу якої входять речовини, що можуть викликати токсичні ефекти, в т.ч. мутагенні та канцерогенні.
За запасами води, доступними для використання, Україна належить до малозабезпечених країн. У маловодні роки на одну людину припадає
0,67 тис.м³ річного стоку. За визначенням Європейської Економічної Комісії ООН, держава, водні ресурси якої не перевищують 1,5 тис.м³ на одного мешканця, вважається водонезабезпеченою. Україна займає передостаннє місце за запасами питної води на душу населення серед країн СНД.
Україна, перебуваючи у несприятливих умовах щодо водних ресурсів, не реалізує жорстких цільових програм стосовно збереження й ощадливого використання запасів питної води. Питоме централізоване водопостачання для населення України досягло 370 л/чол. на добу. Це щонайменше у два рази вище, ніж середній рівень водопостачання у розвинутих країнах світу (середньодобове споживання води одним мешканцем Києва складає 410-450 літрів, тоді як у Барселоні (Іспанія) – 106; Амстердамі (Нідерланди) – 100; Антверпені (Бельгія) – 85 л/чол. на добу. Для підтримки життєдіяльності організму людини потрібно приблизно 2-3 л води на добу. Витрати свіжої води в Україні на одиницю виробленої продукції значно перевищують такі показники у розвинутих країнах Європи: Франції – у 2,5 рази, ФРН – у 4,3 рази, Великобританії та Швеції – у 4,2 рази.

На даний час в Україні існує 4 джерела питного водопостачання:
• централізоване водопостачання;
• поверхневі води (криниці, джерела);
• артезіанські свердловини;
• питна бутильована вода.
Стан НД на питну воду
Серед пріоритетних напрямків економічного розвитку України визначено її інтеграцію у європейську та світову спільноту, що актуалізує питання гармонізації вітчизняних стандартів та законів з діючими міжнародними нормами.
У повній мірі це стосується також питної води.В Україні гігієнічні вимоги до питної води регламентуються
ГОСТ 2874-82 "Вода питьевая. Гигиенические требования и контроль за качеством", який діє з 1984 року. Цей стандарт містить 27 показників якості питної води централізованого водопостачання, для яких встановлені граничнодопустимі значення, регламентує методи відбору проб та періодичність лабораторно-виробничого контролю. Для всіх показників наведені методи випробувань згідно міждержавного стандарту.
Наказом МОЗ України від 23.12.1996 № 383 затверджено ДСанПіН "Вода питна. Гігієнічні вимоги до якості води централізованого господарсько- питного водопостачання". У цьому ДСанПіН встановлені гранично допустимі значення ще для 18 нових показників порівняно з міждержавним стандартом (барій, нікель, тригалогенметани, хлороформ, тетрахлорвуглець, пестициди та інші), а також стали більш жорсткіші норми для деяких показників, регламентованих у міждержавному стандарті. Щоправда, Кабінет Міністрів України передбачив перехідний період протягом п’яти років (з 2000-го до 2005-го) у введені ДСанПіН, тому що за нинішньої фінансової кризи навряд чи вдасться терміново переоснастити водопостачальні об'єкти по всій Україні. Розпорядженням Київської міської державної адміністрації від 04.05.2000 р. № 659 затверджено міський "План організаційно- технічних заходів щодо підвищення ефективності діючих водопровідних споруд та поетапного впровадження в дію ДСанПіН, що розрахований на 2000-
Хіміко-аналітична лабораторія
Визначення токсичних елементів у питній воді (атомно-обсорційний спектрофотометр)
Одним із суттєвих недоліків даних ДСанПіН є відсутність посилань на методи випробувань.
У Російській Федерації постановою Держкомсанепіднагляду РФ від
24.10.1996 був затверджений СанПиН 2.1.4.559-96 "Питьевая вода. Гигиенические требования к качеству воды централизованых систем питьевого водоснабжения. Контроль качества", який введений у дію з 01.07.1997. Прийняття цього документа стало серйозним проривом у справі контролю за якістю питної води в Росії, тому що він був створений на основі останніх розробок і даних російських вчених та з урахуванням рекомендацій ВООЗ. З більшості показників російський СанПиН задовольняє рекомендаціям ВООЗ і не поступає закордонним стандартам, а де в чому навіть і перевищує їх.
Всесвітня Організація Охорони Здоров'я (ВООЗ) – це спеціалізована установа ООН, основною функцією якої є вирішення міжнародних проблем охорони здоров'я населення. "Посібник з контролю якості питної води", виданий цією організацією в 1984 році (переглянутий і доповнений в 1993 році) є основним стандартом, на підставі якого розробляються нормативи інших країн. Нормативи ВООЗ регулярно переглядаються та уточнюються, а кількість нормованих компонентів у питній воді безперервно зростає. Так у першому виданні "Посібника..." у 1984 році були встановлені нормативи для 18 органічних сполук, а в 1993 – для 88.
Директива ЄС 80/778/ЄС "Директива про питну воду" була прийнята Європейською Радою 15.07.1980 і покладена в основу водного законодавства європейських країн – членів ЄС. У Директиві нормуються 66 показників якості питної води. Однак 03.11.1998 Радою ЄС замість цієї Директиви була прийнята нова Директива 98/83/ЄС "Про якість питної води, призначеної для споживання людиною".
Бактеріологічна лабораторія кімната лікарів (середовище ендо- колонії для виявлення бактерій групи кишечної палочки)
У всіх, вищевказаних нормативних документах, у питній воді нормуються слідуючі групи показників:
• загальні фізико-хімічні показники якості води;
• органолептичні показники;
• мікробіологічні і паразитологічні показники якості води;
• радіологічні показники якості води;
• гранично допустимі концентрації вмісту основних
неорганічних речовин у питній воді;
• гранично допустимі концентрації вмісту основних
органічних речовин у питній воді;

• дезінфектанти і продукти знезаражування.
Бактеріологічна лабораторія
(метод мембранної фільтрації)
Порівняння НД України зі стандартами країн ЄС та рекомендаціями ВООЗ показує, що всі вони подібні в частинах, що регламентують вміст неорганічних компонентів, мікробіологічні та радіологічні показники, але значно розрізняються щодо кількості нормованих органічних сполук.
Так, ГОСТ 2874-82 не нормує вміст органічних сполук, у ДСанПіН України введено
7 нормативів для органічних сполук. В той же час, в стандартах на питну воду країн ЄС, російському СанПиН та в рекомендаціях ВООЗ перелік нормованих органічних речовин становить відповідно 11,37 та 88. Національний стандарт, який би регламентував вимоги до якості та безпечності питної води, відсутній, як відсутній навіть і проект такого стандарту.
Хромотографічна лабораторія
Газовий хромотомаз спектометр (визначення пестицидів та поліциклічні ароматичні вугливоди)
Спеціалістами Укрметртестстандарту був розроблений Проект Технічного регламенту «Вимоги до фасованих природних мінеральних, джерельних та інших питних вод, їх виробництва і обігу», який був направлений в Держспоживстандарт України для розгляду і узгодження, проте відповіді щодо цього регламенту не отримано і подальша його доля невідома.
Стан НД на воду фасовану (бутильовану) питну, що розливається в Україні, є незадовільний. Сьогодні в Україні фасовану (бутильовану) воду розливають більше 300 виробників. Більшість з них розробили та зареєстрували свої власні ТУ. В Україні на воду фасовану (бутильовану) питну зареєстровано 538 технічних умов. Головним недоліком таких ТУ є те, що гігієнічні нормативи якості води, що нормуються МОЗ України, беруться із ГОСТ 2874-82, який поширюється тільки на воду питну централізованого водопостачання. Відсутній поділ фасованої (бутильованої) води на групи, а як наслідок і незрозуміла цінова політика виробників.
На даний час, кінцева редакція національного стандарту, який регламентує вимоги до вод питних фасованих (бутильованих), на розгляді в Держспоживстандарті України.
Маємо надію, що найближчим часом цейстандарт набуде чинності в Україні.
Облік води
Україна займає передостаннє місце за запасами питної води на душу населення серед країн СНД, тому раціональне споживання води стало життєво необхідним. Облік води, за допомогою приладів, дозволяє розробити та здійснити організаційні та технічні заходи, направлені на її економію.
Отже, на 1 січня 2007 року до державного реєстру засобів вимірювальної техніки занесено 107 типів квартирних лічильників холодної та гарячої води, з них вітчизняного виробництва – 41 тип, імпортованих – 66 типів. Для вирішення питання обліку води була прийнята «Програма поетапного оснащення наявного житлового фонду засобами обліку та регулювання споживання води і теплової енергії на 1996-2007 роки», затверджена Постановами Кабінету Міністрів України від 27.11.95 № 947, від 19.10.98
№ 1657 та від 25.12.2002 № 1957. Цими Програмами передбачається установити до 2007 року в наявному житловому фонді м. Києва 3755 од. будинкових лічильників холодної води і 7130 од. будинкових лічильників гарячої води, а також 63629 од. квартирних лічильників холодної води і 41615 од. лічильників гарячої води.
У м. Києві наприкінці 2006 року, лічильниками холодної води було обладнано 8703 будинки, лічильниками гарячої – 1616.
Конструкція типового будинкового лічильника
6
На 01.08.2007 у м. Києві було встановлено 395188 квартирних лічильників холодної води та 377679 квартирних лічильників гарячої води.
Враховуючи, що у м. Києві налічується 10352 багатоквартирні будинки і975939 квартир, можна сказати, оснащеність житлового фонду засобами обліку складає:
– будинковими лічильниками холодної води – 84 %;
– будинковими лічильниками гарячої води – 15,6 %;
– квартирними лічильниками холодної води – 40,5 %;

– квартирними лічильниками гарячої води – 39 %.
Конструкція лічильника, що розрахований на споживання води у широкому діапазоні.
Таке низьке оснащення будинків лічильниками гарячої води пояснюється тим, що на теперішній час законодавчо не визначено виконавця послуги
«гаряче водопостачання»: Водоканал відповідає тільки за холодну воду, а Київенерго – тільки за підігрів цієї води до відповідної температури. Це питання потребує якнайшвидшого вирішення. Слід відмітити, що вже є досвід вирішення цього питання у країнах СНГ. Постановою Уряду Москви від
10.02.2004 № 77-ПП організації, які готують гарячу воду, назначено виконавцями послуги «гаряче водопостачання», ці організації закуповують у
«Мосводоканалі» холодну воду (за затвердженими тарифами) і несуть відповідальність за параметри гарячої води. Нажаль, в Україні не вирішено на державному рівні питання про виконавця послуги «гаряче водопостачання», КДМА та АЕК «Київенерго» вимушені проводити певні роботи для розв’язання цього питання на рівні м.
безпосередню участь у цих роботах, щодо метрологічного забезпечення.
Основне джерело фінансування на встановлення будинкових лічильників холодної води - Київводоканал, а квартирних – кошти мешканців. Але в Україні відсутня система проведення робіт із встановлення та подальшого технічного обслуговування спеціалізованими організаціями, які мають відповідне технічне обладнання, обмінний фонд лічильників, кваліфікованих фахівців. Тому мешканці квартир, які вирішили установити лічильники води, витрачають багато власного часу на організацію робіт із установлення, технічного обслуговування та повірки лічильників води.
Після того, як мешканець за свої кошти придбав і установив лічильники,
представник ЖЕКу повинен їх опломбувати і взяти на облік.
Враховуючи, що за показниками квартирних лічильників води проводяться розрахунки між споживачами і виконавцями послуг, ці прилади підлягають періодичній повірці в територіальних органах Держспоживстандарту України. Для проведення повірки необхідно виконати такі дії:
- на ім’я начальника ЖЕКу необхідно написати три заяви: одну – з проханням зняти, а потім знову установити пломби на приладах, другу – із замовленням на демонтаж лічильників, третю – на їх повторне установлення. Після цього заяви потрібно віднести диспетчеру. Як тільки пломби будуть зняті, лічильники необхідно відвезти до ДП Укрметртестстандарту, де їх повірять протягом одного-двох днів. Після цього необхідно надати диспетчеру заяви на установку лічильників і їх опломбування.
- повірка не обов’язково завершиться позитивним результатом.
Якщо результати повірки будуть негативними, лічильник необхідно здавати у ремонт, або придбати новий.
Незважаючи на такі клопоти, зростає число мешканців, що за свої кошти встановлюють квартирні лічильники води.
Але при відсутності лічильників оплата за воду проводиться за нормами
споживання. У Києві норми споживання такі: 5,5 кубічних метра холодної
8
води і 3,5 кубічних метра гарячої води, на одну особу в місяць. Реальне споживання води, яке визначається за показами лічильників, у більшості випадків значно менше. Окрім того, при встановленні лічильників води спрацьовує психологічний фактор, коли споживач починає раціонально використовувати воду, що сприяє економії води.
У разі встановлення будинкових засобів обліку води у багатоквартирному будинку, де окремі квартири обладнані квартирними засобами обліку, споживач, який не має квартирних засобів обліку, оплачує послуги згідно з показниками будинкових засобів обліку, не враховуючи витрати води виконавця, юридичних осіб та фізичних осіб - підприємців, які є власниками або орендарями приміщень у цьому будинку, та сумарних витрат води за показниками усіх квартирних засобів обліку. Різниця розподіляється між споживачами, які не мають квартирних засобів обліку, пропорційно кількості мешканців квартири в разі відсутності витоків із загальної мережі будинку, що підтверджується актом обстеження, який складається виконавцем у присутності не менш як двох мешканців.
Зазвичай такі акти складаються при аварійних витоках, але витоки спричинені несправними сантехнічними виробами, нещільними засувками тощо, розподіляються між мешканцями, що не мають лічильників води, незалежно від того чи ці витоки наявні у їхній квартирі.
Під час експлуатації лічильники води необхідно повіряти періодично з міжповірочним інтервалом, що встановлюється для кожного конкретного типу лічильника води. Укрметртестстандарт проводить роботи з експериментального підтвердження метрологічно і економічно обґрунтованого міжповірочного інтервалу.
За дорученням Держспоживстандарту України, ДП Укрметртестстандарт розробив Інструкцію “Контроль метрологічних характеристик лічильників води, що поступають на повірку з експлуатації”, згідно якої здійснювався контроль похибки лічильників води у 28-и територіальних органах Держспоживстандарту України та комунальних господарствах
Держжитлокомунгоспу України.
9
Було проконтрольовано метрологічні характеристики 162619 квартирних лічильників води, що поступили на періодичну повірку.
При цьому виявлено, що хоча до Державного реєстру засобів вимірювальної техніки України занесено 72 типи квартирних лічильників води, практичне застосування знайшли біля 30 типів.При контролі зовнішнього вигляду і метрологічних характеристик 39,7 % лічильників холодної та гарячої води (крильчастих) були визнані непридатними до використання.
Процент лічильників, визнані непридатними до застосування за зовнішнім видом
![]()
Процент лічильників, похибка яких перевищує 2*DELTA
![]()
Процент лічильників, похибка яких лежить в інтервалі між DELTA та 2*DELTA
![]()
Процент лічильників, похибка яких менше DELTA

13,0 %
12,6 %
60,3 %
14,1 %
де DELTA - границі допустимої похибки лічильників води
За результатами проведених досліджень було видано спільний наказ Держспоживстандарту, Мінпромполітики та Держжитлокомунгоспу від 15 червня 2005 року № 141/212/91, яким доручається провести випробування лічильників води (крильчастих) прискореним методом для можливості збільшення міжповірочного інтервалу.
Для експериментального підтвердження встановленого міжповірочного інтервалу лічильників води, ДП «Укрметртестстандарт» за власні кошти виготовив випробувальну установку для проведення дослідження цих приладів на прискорене зношування.
100 тисяч послідовних пусків-зупинок на номінальній витраті, а після цього
100 годин роботи на максимальній витраті. При проведенні експериментальних досліджень лічильники води піддаються впливу умов аналогічних не менше
10
ніж п’яти-восьми рокам експлуатації. Лічильникам, результати випробувань яких на прискорене зношування позитивні, встановлюється міжповірочний інтервал 4 роки.

Таким чином, роботи, що проводяться Укрметртестстандартом, дадуть змогу зберегти час та кошти споживачів.
Загальний вигляд установки для випробувань лічильників води на прискорене зношування.
Повірка, державні випробуваня лічильників води, а також дослідження метрологічних характеристик лічильників води у рамках проведення науково- дослідних робіт виконуються на робочих еталонах – проливних установках.
Загальний вигляд робочого еталона – проливної установки.
Укрметртестстандарт за свої кошти придбав і ввів у експлуатацію три проливні установки.
Усі ці установки автоматизовані та дозволяють проводити повірку лічильників води з номінальними діаметрами від DN15 до DN100.
У 2006 році установку ALEX-132-40/16U було затверджено у якості вторинного еталона одиниць об’ємної витрати рідини в діапазоні від 2,77⋅10-6
м3/с до 4,44⋅10-3 м3/с, масової витрати рідини в діапазоні від 2,77⋅10-3 кг/с до
11
4,44 кг/с, об’єму рідини в діапазоні від 5⋅10-3 м3 до 0,4 м3 та маси рідини в
діапазоні від 5 кг до 400 кг, що протікає по трубопроводу.
Загальний вигляд вторинного еталона.
До Плану розвитку еталонної бази на 2007-2010 роки внесено розробку Укрметртестстандартом Державного первинного еталона одиниці об’єму, маси, об’ємної та масової витрати гарячої води.
У 2006 році Укрметртестстандарт ввів у експлуатацію проливну установку PREMATEST, для гарячої води, що дозволяє проводити повірку та випробування лічильників за температури до 85 оС. Наказом Держспоживстандарту від 22 серпня 2007 року N 193 цю установку було затверджено як вихідний еталон України, тобто еталон з найвищою в Україні точністю.
Загальний вигляд вихідного еталона.
Окрім Укрметртестстандарту проливні установки є на підприємствах- виробниках лічильників води та в організаціяї, які займаються монтажем та обслуговуванням лічильників. Усі ці підприємства проводять роботи з
підготовки лічильників води до повірки – регулювання, ремонт тощо.
12
Але повірку на обладнанні цієї організації виконує державний повірник –
представник Укрметртестстандарту.
У м. Києві шість підприємств випускають квартирні лічильники води. При визначенні достатнього джерела фінансування робіт з встановлення квартирних лічильників води ці підприємства за короткий час можуть забезпечити м. Київ лічильниками води в повному обсязі.
За 2006 рік Укрметртестстандарт повірив 114507 одиниць лічильників холодної та гарячої води. Питання метрологічного забезпечення обліку води в м. Києві, Укрметртестстандарт вирішує шляхом нарощування еталонної бази відповідно до збільшення парку приладів обліку води.
Порядок оплати робіт з повірки і монтажу-демонтажу лічильників регламентується у таких нормативних документах:
1) Згідно з статтею 28 Закону України «Про метрологію та метрологічну діяльність» періодична повірка, обслуговування та ремонт (у тому числі демонтаж, транспортування та монтаж) лічильників води здійснюється за рахунок підприємств і організацій, які надають послуги з водопостачання;
2) Згідно з Правилами надання послуг з централізованого опалення, постачання холодної та гарячої води і водовідведення, затвердженими Постановою Кабінету Міністрів України від 21.06.2005 № 630 періодична повірка, обслуговування та ремонт (в тому числі демонтаж, транспортування та монтаж) квартирних засобів обліку проводяться за рахунок виконавця послуг;
3) Згідно з Порядком формування тарифів на послуги з утримання будинків і споруд та прибудинкових територій, затвердженим Постановою Кабінету Міністрів України від 12.06.2005 № 560 витрати на періодичну повірку, обслуговування і ремонт (у тому числі демонтаж, транспортування та монтаж після повірки) квартирних засобів обліку води та теплової енергії, враховуються під час розрахунку нормативних витрат при формуванні тарифів і визначаються відповідно до укладених договорів між власником (балансоутримувачем) будинку або його уповноваженою особою та
організацією, яка здійснює зазначені роботи.
13
ДП Укрметртестстандарт вважає, що Постанова № 560 разом із Правилами надання послуг з централізованого опалення, постачання холодної та гарячої води і водовідведення, затвердженими Постановою Кабінету Міністрів України від 21 липня 2005 року № 630 достатні для нормативного регулювання порядку та джерел фінансування проведення повірки квартирних лічильників води.
Стосовно організаційних питань, що знаходяться поза межами компетенції Укрметртестстандарту є такі пропозиції.
На рівні Держави:
1. На законодавчому рівні визначити виконавця послуги «гаряче водопостачання».
2. Розробити Правила обліку відпускання та споживання холодної та гарячої води на усіх об’єктах систем холодного та гарячого водопостачання, починаючи з водопостачальної організації аж до кінцевих споживачів - мешканців квартир багатоквартирних будинків.
На рівні міста Києва:
1. На рівні КМДА вирішити питання про створення сервісних центрів для встановлення лічильників води та їх обслуговування під час експлуатації, як це зроблено у всіх розвинених країнах. Створення у цих центрах обмінного фонду лічильників води, дозволить скоротити час і кошти, що витрачаються демонтаж та подальший монтаж лічильників води в квартирі мешканця.
2. На рівні КМДА вирішити питання про укладання договорів:
– між балансоутримувачем та сервісним центром;
– між балансоутримувачем та кінцевим споживачем.
Комментарии